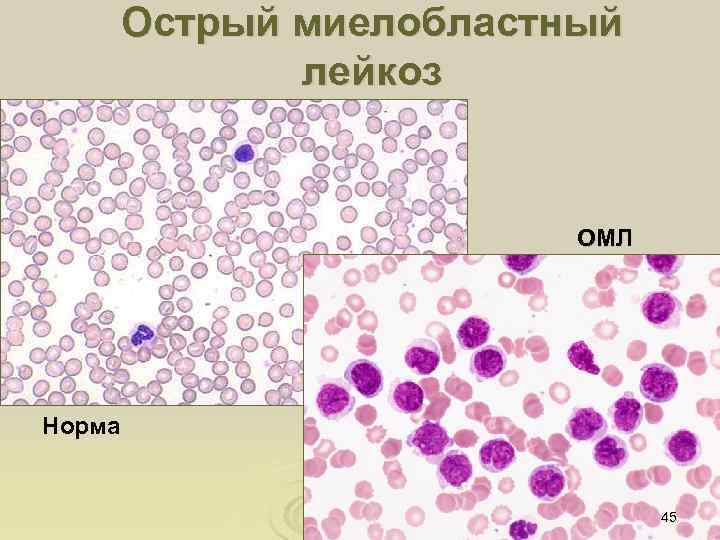
Острый миелобластный лейкоз ОМЛ Норма 45
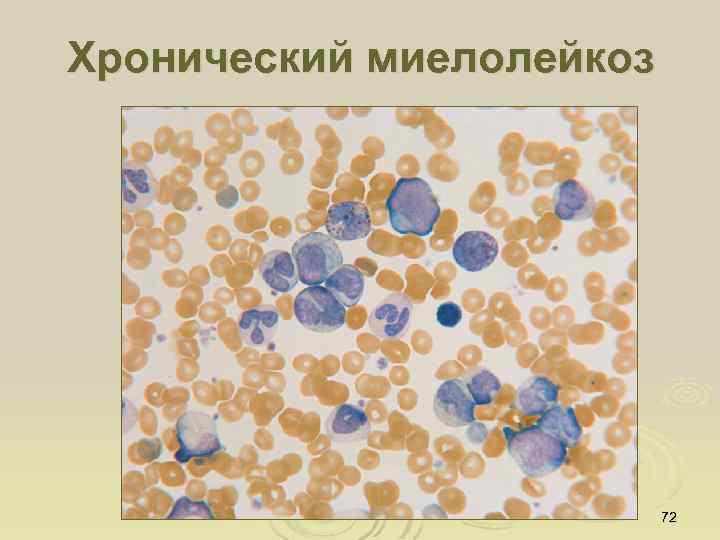
Хронический миелолейкоз 72

1_11_03_13_Leykozy_leykotsitozy.ppt
- Количество слайдов: 88
 Лейкоцитозы, лейкопении, лейкозы, 1
Лейкоцитозы, лейкопении, лейкозы, 1
 2
2
 Показатели крови в норме Количество эритроцитов М 4, 5– 5, 0 х1012/л Ж 4, 0– 4, 5 х1012/л Ретикулоциты % Нормобласты нет Гемоглобин М 130 – 160 г/л Ж 120 – 160 г/л Анизоцитоз нет Микроцитоз нет Макроцитоз нет Пойкилоцитоз нет Тельца Жолли нет Кольца Кабо нет Мегалобласты нет Мегалоциты нет ЦП – (цветовой показатель) 0, 85 -1, 0 Тромбоциты 150 -380 х109/л СОЭ 0 - 15 мм/ч 0, 2 -1 НЕЙТРОФИЛЫ Б Количество лейкоцитов 4 -9 х109/л Э М Ю П С Л М 0 -1 1 -3 0 0 3 -5 54 -63 25 -35 4 -8 1, 2 3, 0 0, 09 0, 6 абс. величины (× 109/л) 0 0, 065 0, 04 0, 3 0, 12 0, 45 2, 0 5, 0 3
Показатели крови в норме Количество эритроцитов М 4, 5– 5, 0 х1012/л Ж 4, 0– 4, 5 х1012/л Ретикулоциты % Нормобласты нет Гемоглобин М 130 – 160 г/л Ж 120 – 160 г/л Анизоцитоз нет Микроцитоз нет Макроцитоз нет Пойкилоцитоз нет Тельца Жолли нет Кольца Кабо нет Мегалобласты нет Мегалоциты нет ЦП – (цветовой показатель) 0, 85 -1, 0 Тромбоциты 150 -380 х109/л СОЭ 0 - 15 мм/ч 0, 2 -1 НЕЙТРОФИЛЫ Б Количество лейкоцитов 4 -9 х109/л Э М Ю П С Л М 0 -1 1 -3 0 0 3 -5 54 -63 25 -35 4 -8 1, 2 3, 0 0, 09 0, 6 абс. величины (× 109/л) 0 0, 065 0, 04 0, 3 0, 12 0, 45 2, 0 5, 0 3
 Пять видов лейкоцитов, выявляемых в периферической крови в норме Гранулоциты 4
Пять видов лейкоцитов, выявляемых в периферической крови в норме Гранулоциты 4
 Морфология клеток гранулоцитарного ростка кроветворения Н - нейтрофилы Э - эозинофилы Б - базофилы 5
Морфология клеток гранулоцитарного ростка кроветворения Н - нейтрофилы Э - эозинофилы Б - базофилы 5
 Морфология клеток моноцитарного ростка кроветворения 6
Морфология клеток моноцитарного ростка кроветворения 6
 Морфология клеток лимфоидного ростка кроветворения 7
Морфология клеток лимфоидного ростка кроветворения 7
 Лейкоциты периферической крови Базофил Эозинофил Нейтрофил Лимфоцит Моноцит НЕЙТРОФИЛЫ Б Количество лейкоцитов 4 -9 х109/л Э М Ю П С Л М 0 -1 1 -3 0 0 3 -5 54 -63 25 -35 4 -8 1, 2 3, 0 0, 09 0, 6 абс. величины (× 109/л) 0 0, 065 0, 04 0, 3 0, 12 0, 45 2, 0 5, 0 8
Лейкоциты периферической крови Базофил Эозинофил Нейтрофил Лимфоцит Моноцит НЕЙТРОФИЛЫ Б Количество лейкоцитов 4 -9 х109/л Э М Ю П С Л М 0 -1 1 -3 0 0 3 -5 54 -63 25 -35 4 -8 1, 2 3, 0 0, 09 0, 6 абс. величины (× 109/л) 0 0, 065 0, 04 0, 3 0, 12 0, 45 2, 0 5, 0 8
 Лейкоцитоз Ø Увеличение количества лейкоцитов в периферической крови - проявление реакции системы крови на действие физиологических стимулов или патологических факторов Ø Виды лейкоцитоза l l Физиологический Патологический 9
Лейкоцитоз Ø Увеличение количества лейкоцитов в периферической крови - проявление реакции системы крови на действие физиологических стимулов или патологических факторов Ø Виды лейкоцитоза l l Физиологический Патологический 9
 Механизмы лейкоцитоза • выход лейкоцитарного резерва из костного мозга • стимуляция пролиферации лейкоцитов в костном мозге • уменьшение адгезии лейкоцитов к эндотелию и их выхода в ткани • переход лейкоцитов из маргинального пула в циркулирующий • миело- и лимфопролиферативные процессы 10
Механизмы лейкоцитоза • выход лейкоцитарного резерва из костного мозга • стимуляция пролиферации лейкоцитов в костном мозге • уменьшение адгезии лейкоцитов к эндотелию и их выхода в ткани • переход лейкоцитов из маргинального пула в циркулирующий • миело- и лимфопролиферативные процессы 10
 Физиологический лейкоцитоз Ø Сопровождает физиологические процессы и наблюдается у здоровых людей при определенном функциональном состоянии l l Эмоциональный Миогенный Пищеварительный При беременности По клеточному составу обычно нейтрофильный, без изменения лейкоцитарной формулы Ø По механизму – чаще перераспределительный Ø 11
Физиологический лейкоцитоз Ø Сопровождает физиологические процессы и наблюдается у здоровых людей при определенном функциональном состоянии l l Эмоциональный Миогенный Пищеварительный При беременности По клеточному составу обычно нейтрофильный, без изменения лейкоцитарной формулы Ø По механизму – чаще перераспределительный Ø 11
 Патологический лейкоцитоз Ø Сопровождает ряд патологических процессов. Характерно появление незрелых форм лейкоцитов Ø По клеточному составу l l l Гранулоцитарный (нейтрофильный, эозинофильный, базофильный) Моноцитарный (моноцитоз) Лимфоцитарный (лимфоцитоз) 12
Патологический лейкоцитоз Ø Сопровождает ряд патологических процессов. Характерно появление незрелых форм лейкоцитов Ø По клеточному составу l l l Гранулоцитарный (нейтрофильный, эозинофильный, базофильный) Моноцитарный (моноцитоз) Лимфоцитарный (лимфоцитоз) 12
 Лейкоцитоз 13
Лейкоцитоз 13
 Нейтрофильный лейкоцитоз Увеличение количества циркулирующих нейтрофилов >7, 5*109/л, нередко с появлением незрелых миелоидных клеток, иногда – токсической зернистости Ø Ø Ø Ø инфекционные заболевания воспаление неинфекционной природы (острый инфаркт миокарда, васкулиты, миозиты) тяжелые ожоги электротравма метаболические нарушения (ацидоз, уремия, подагра) гемолитические анемии или острые постгеморрагические анемии на фоне терапии кортикостероидами злокачественные опухоли (с метастазами, присоединении вторичной инфекции) 14
Нейтрофильный лейкоцитоз Увеличение количества циркулирующих нейтрофилов >7, 5*109/л, нередко с появлением незрелых миелоидных клеток, иногда – токсической зернистости Ø Ø Ø Ø инфекционные заболевания воспаление неинфекционной природы (острый инфаркт миокарда, васкулиты, миозиты) тяжелые ожоги электротравма метаболические нарушения (ацидоз, уремия, подагра) гемолитические анемии или острые постгеморрагические анемии на фоне терапии кортикостероидами злокачественные опухоли (с метастазами, присоединении вторичной инфекции) 14
 Дегенеративные формы нейтрофилов а - токсическая зернистость нетрофилов, б - нетрофилы с вакуолизацией цитоплазмы 15
Дегенеративные формы нейтрофилов а - токсическая зернистость нетрофилов, б - нетрофилы с вакуолизацией цитоплазмы 15
 Гиперсегментированный нейтрофил 16
Гиперсегментированный нейтрофил 16
 Эозинофилия 17
Эозинофилия 17
 Механизмы эозинофилии Ø Ø Иммунный, опосредуемый Ig. E при аллергии Антителозависимый (Ig. A или Ig. G) хемотаксис при паразитозах Ответ на эозинофильный хемотаксический фактор, выделяемый некоторыми опухолями Опухолевая эозинофилия (эозинофильный росток является морфологическим субстратом опухоли) 18
Механизмы эозинофилии Ø Ø Иммунный, опосредуемый Ig. E при аллергии Антителозависимый (Ig. A или Ig. G) хемотаксис при паразитозах Ответ на эозинофильный хемотаксический фактор, выделяемый некоторыми опухолями Опухолевая эозинофилия (эозинофильный росток является морфологическим субстратом опухоли) 18
 БАВ эозинофилов Главный основной белок (MBP) Катионный белок (ECP) Паразитоцидное Нейротоксин (белок Х) действие Миелопероксидаза Гистаминаза Арилсульфатаза Пероксидаза Фосфолипазы В, D Кининаза Карбоксипептидазы N Инактивация медиаторов воспаления и аллергии 19
БАВ эозинофилов Главный основной белок (MBP) Катионный белок (ECP) Паразитоцидное Нейротоксин (белок Х) действие Миелопероксидаза Гистаминаза Арилсульфатаза Пероксидаза Фосфолипазы В, D Кининаза Карбоксипептидазы N Инактивация медиаторов воспаления и аллергии 19
 Патологические изменения при гиперэозинофилии Ø Эозинофильный васкулит Ø Пристеночный фибропластический эндокардит Ø Нарушения в системе гемостаза гиперкоагуляция 20
Патологические изменения при гиперэозинофилии Ø Эозинофильный васкулит Ø Пристеночный фибропластический эндокардит Ø Нарушения в системе гемостаза гиперкоагуляция 20
 эозинофилия Количество эритроцитов Ретикулоциты % 0, 8 Нормобласты 2, 7 х1012/л нет Анизоцитоз Гемоглобин ЦП – (цветовой показатель) Тромбоциты нет Пойкилоцитоз нет Мегалоциты 50 мм/ч + Мегалобласты 180 х109/л СОЭ ++ Макроцитоз 1, 0 + Микроцитоз 90 г/л нет НЕЙТРОФИЛЫ Количество лейкоцитов Б Э М Ю П С Л М 10 х109/л 0 40 0 0 3 30 20 7 21
эозинофилия Количество эритроцитов Ретикулоциты % 0, 8 Нормобласты 2, 7 х1012/л нет Анизоцитоз Гемоглобин ЦП – (цветовой показатель) Тромбоциты нет Пойкилоцитоз нет Мегалоциты 50 мм/ч + Мегалобласты 180 х109/л СОЭ ++ Макроцитоз 1, 0 + Микроцитоз 90 г/л нет НЕЙТРОФИЛЫ Количество лейкоцитов Б Э М Ю П С Л М 10 х109/л 0 40 0 0 3 30 20 7 21
 Базофилия 22
Базофилия 22
 Абсолютная базофилия более 150/мкл • гиперчувствительность немедленного типа • контактные дерматиты • неспецифический язвенный колит • коллагенозы • тиреоидит • миелопролиферативные заболевания 23
Абсолютная базофилия более 150/мкл • гиперчувствительность немедленного типа • контактные дерматиты • неспецифический язвенный колит • коллагенозы • тиреоидит • миелопролиферативные заболевания 23
 Моноцитоз Увеличение количества циркулирующих моноцитов >0, 45*109/л: Ø инфекционный мононуклеоз Ø хронические бактериальные инфекции Ø протозойные инфекции Ø краснуха 24
Моноцитоз Увеличение количества циркулирующих моноцитов >0, 45*109/л: Ø инфекционный мононуклеоз Ø хронические бактериальные инфекции Ø протозойные инфекции Ø краснуха 24
 Лимфоцитоз Увеличение количества циркулирующих лимфоцитов >3, 5*109/л: Ø Ø Ø туберкулез сифилис Бруцеллез инфекционный лимфоцитоз коклюш инфекционный мононуклеоз 25
Лимфоцитоз Увеличение количества циркулирующих лимфоцитов >3, 5*109/л: Ø Ø Ø туберкулез сифилис Бруцеллез инфекционный лимфоцитоз коклюш инфекционный мононуклеоз 25
 Инфекционный мононуклеоз Вирус Эпштейн-Барр 26
Инфекционный мононуклеоз Вирус Эпштейн-Барр 26
 Лейкемоидные реакции Значительное реактивное увеличение числа лейкоцитов периферической крови (>20*109/л) с появлением незрелых форм лейкоцитов Типы лейкемоидных реакций: Ø Миелоидный Ø Лимфоидный 27
Лейкемоидные реакции Значительное реактивное увеличение числа лейкоцитов периферической крови (>20*109/л) с появлением незрелых форм лейкоцитов Типы лейкемоидных реакций: Ø Миелоидный Ø Лимфоидный 27
 Лейкемоидная реакция нейтрофильного типа Количество эритроцитов Ретикулоциты % ЦП – (цветовой показатель) + Макроцитоз нет Пойкилоцитоз нет Мегалоциты 34 мм/ч + Мегалобласты 230 х109/л СОЭ + Микроцитоз 0, 82 Тромбоциты нет Анизоцитоз 96 г/л Гемоглобин 0, 7 Нормобласты 3, 5 х1012/л нет НЕЙТРОФИЛЫ Количество лейкоцитов Б Э М Ю П С Л М 37 х109/л 0 1 4 15 29 41 4 5 Промиелоциты – 1% 28
Лейкемоидная реакция нейтрофильного типа Количество эритроцитов Ретикулоциты % ЦП – (цветовой показатель) + Макроцитоз нет Пойкилоцитоз нет Мегалоциты 34 мм/ч + Мегалобласты 230 х109/л СОЭ + Микроцитоз 0, 82 Тромбоциты нет Анизоцитоз 96 г/л Гемоглобин 0, 7 Нормобласты 3, 5 х1012/л нет НЕЙТРОФИЛЫ Количество лейкоцитов Б Э М Ю П С Л М 37 х109/л 0 1 4 15 29 41 4 5 Промиелоциты – 1% 28
 Патогенетическое значение лейкоцитоза Ø Показатель реактивности организма Ø Защитное (воспаление) Ø Диагностическое (в частности индикатор эндотоксикоза) Ø Нарушение микроциркуляции, повышение адгезии к эндотелию 29
Патогенетическое значение лейкоцитоза Ø Показатель реактивности организма Ø Защитное (воспаление) Ø Диагностическое (в частности индикатор эндотоксикоза) Ø Нарушение микроциркуляции, повышение адгезии к эндотелию 29
 Лейкопения МЕХАНИЗМЫ • нарушение образования лейкоцитов в костном мозге • нарушение созревания и выхода лейкоцитов из костного мозга • перераспределение и уменьшение циркулирующего пула • разрушение лейкоцитов в кровеносном русле • увеличение выхода лейкоцитов из кровеносного русла 30
Лейкопения МЕХАНИЗМЫ • нарушение образования лейкоцитов в костном мозге • нарушение созревания и выхода лейкоцитов из костного мозга • перераспределение и уменьшение циркулирующего пула • разрушение лейкоцитов в кровеносном русле • увеличение выхода лейкоцитов из кровеносного русла 30
 Панцитопения Гемоглобин ЦП – (цветовой показатель) 0, 84 Тромбоциты нет ++ нет Пойкилоцитоз нет Мегалоциты 24 мм/ч + Мегалобласты 60 х109/л СОЭ Нормобласты Макроцитоз 56 г/л 0, 3 Анизоцитоз 2, 0 х1012/л Ретикулоциты % Микроцитоз Количество эритроцитов нет НЕЙТРОФИЛЫ Количество лейкоцитов Б Э М Ю П С Л М 2, 1 х109/л 0 1 0 0 0 28 66 5 31
Панцитопения Гемоглобин ЦП – (цветовой показатель) 0, 84 Тромбоциты нет ++ нет Пойкилоцитоз нет Мегалоциты 24 мм/ч + Мегалобласты 60 х109/л СОЭ Нормобласты Макроцитоз 56 г/л 0, 3 Анизоцитоз 2, 0 х1012/л Ретикулоциты % Микроцитоз Количество эритроцитов нет НЕЙТРОФИЛЫ Количество лейкоцитов Б Э М Ю П С Л М 2, 1 х109/л 0 1 0 0 0 28 66 5 31
 Агранулоцитоз Количество эритроцитов 3, 7 х1012/л Ретикулоциты % 0, 6 Нормобласты нет Анизоцитоз Гемоглобин ЦП – (цветовой показатель) Тромбоциты СОЭ нет Мегалобласты нет Мегалоциты 31 мм/ч нет Пойкилоцитоз 300 х109/л нет Макроцитоз 0, 89 + Микроцитоз 110 г/л нет НЕЙТРОФИЛЫ Количество лейкоцитов Б Э М Ю П С Л М 1, 5 х109/л 0 0 0 1 90 9 32
Агранулоцитоз Количество эритроцитов 3, 7 х1012/л Ретикулоциты % 0, 6 Нормобласты нет Анизоцитоз Гемоглобин ЦП – (цветовой показатель) Тромбоциты СОЭ нет Мегалобласты нет Мегалоциты 31 мм/ч нет Пойкилоцитоз 300 х109/л нет Макроцитоз 0, 89 + Микроцитоз 110 г/л нет НЕЙТРОФИЛЫ Количество лейкоцитов Б Э М Ю П С Л М 1, 5 х109/л 0 0 0 1 90 9 32
 Пять видов лейкоцитов, выявляемых в периферической крови в норме Гранулоциты 33
Пять видов лейкоцитов, выявляемых в периферической крови в норме Гранулоциты 33
 Патогенетическое значение лейкопении Ø уменьшение неспецифической резистентности Ø уменьшение выраженности лихорадки (при глубокой нейтропении) Ø крайне неблагоприятно сочетание нейтропении с функциональной неполноценностью лейкоцитов 34
Патогенетическое значение лейкопении Ø уменьшение неспецифической резистентности Ø уменьшение выраженности лихорадки (при глубокой нейтропении) Ø крайне неблагоприятно сочетание нейтропении с функциональной неполноценностью лейкоцитов 34
 Лейкозы Опухоли из кроветворных клеток с первичной локализацией в костном мозге, характеризующиеся неконтролируемым ростом и нарушением дифференцировки 35
Лейкозы Опухоли из кроветворных клеток с первичной локализацией в костном мозге, характеризующиеся неконтролируемым ростом и нарушением дифференцировки 35
 ЛЕЙКОЗЫ ОСТРЫЙ ЛЕЙКОЗ Характеризуется пролиферацией клеток опухолевого клона без дифференцировки. Опухоль состоит из клеток II, IV класса ХРОНИЧЕСКИЙ ЛЕЙКОЗ Характеризуется сохранением способности клеток опухолевого клона к дифференцировке. Опухоль состоит, главным образом, из морфологически зрелых клеток 36
ЛЕЙКОЗЫ ОСТРЫЙ ЛЕЙКОЗ Характеризуется пролиферацией клеток опухолевого клона без дифференцировки. Опухоль состоит из клеток II, IV класса ХРОНИЧЕСКИЙ ЛЕЙКОЗ Характеризуется сохранением способности клеток опухолевого клона к дифференцировке. Опухоль состоит, главным образом, из морфологически зрелых клеток 36
 Структура заболеваемости Количество наблюдений 31, 500 37
Структура заболеваемости Количество наблюдений 31, 500 37
 Тромбоциты лейкоциты Тромбоциты Эритроциты Норма Лейкоциты Эритроциты Бластные клетки Острый лейкоз 38
Тромбоциты лейкоциты Тромбоциты Эритроциты Норма Лейкоциты Эритроциты Бластные клетки Острый лейкоз 38
 Костный мозг при остром лейкозе 39
Костный мозг при остром лейкозе 39
 Этиология лейкозов 1. Мутагенные факторы l l l 2. Наследственная предрасположенность l l 3. ионизирующее излучение канцерогенные вещества онкогенные вирусы (Т-клеточный лимфолейкоз взрослых - HLTV-1; ОЛЛ, лимфома - герпес (ДНК), вирус Эпштейна. Барр и др. ) хромосомные аберрации (трисомия 21, и др. ) хромосомная нестабильность (синдром Блума, Фанкони и др. ) Снижение противоопухолевого иммунитета 40
Этиология лейкозов 1. Мутагенные факторы l l l 2. Наследственная предрасположенность l l 3. ионизирующее излучение канцерогенные вещества онкогенные вирусы (Т-клеточный лимфолейкоз взрослых - HLTV-1; ОЛЛ, лимфома - герпес (ДНК), вирус Эпштейна. Барр и др. ) хромосомные аберрации (трисомия 21, и др. ) хромосомная нестабильность (синдром Блума, Фанкони и др. ) Снижение противоопухолевого иммунитета 40
 Патогенез лейкозов Ø образование онкогенов Ø утрата генов–супрессоров пролиферации Ø нарушение апоптоза l l стимуляция генов, отменяющих апоптоз утрата функции генов апоптоза 41
Патогенез лейкозов Ø образование онкогенов Ø утрата генов–супрессоров пролиферации Ø нарушение апоптоза l l стимуляция генов, отменяющих апоптоз утрата функции генов апоптоза 41
 ЛЕЙКОЗЫ Острые лейкозы ОЛЛ Миелодиспластический синдром Оне. ЛЛ Хронические лейкозы ХМПЗ ХЛЛ М 0 М 1 … М 7 L 1 L 2 L 3 ХМЛ ХМФ ИП ЭТ ХММЛ 42
ЛЕЙКОЗЫ Острые лейкозы ОЛЛ Миелодиспластический синдром Оне. ЛЛ Хронические лейкозы ХМПЗ ХЛЛ М 0 М 1 … М 7 L 1 L 2 L 3 ХМЛ ХМФ ИП ЭТ ХММЛ 42
 ФАБ классификация Оне. ЛЛ (ОМЛ) М 0 – недифференцированный М 1 – без созревания (миелобласты) М 2 – с частичной дифференцировкой (созреванием) М 3 – промиелоцитарный М 4 – миеломонобластный М 5 – монобластный М 6 – эритробластный М 7 - мегакариобластный 43
ФАБ классификация Оне. ЛЛ (ОМЛ) М 0 – недифференцированный М 1 – без созревания (миелобласты) М 2 – с частичной дифференцировкой (созреванием) М 3 – промиелоцитарный М 4 – миеломонобластный М 5 – монобластный М 6 – эритробластный М 7 - мегакариобластный 43
 44
44
Острый миелобластный лейкоз ОМЛ Норма 45
Острый миелобластный лейкоз ОМЛ Норма 45
 Промиелоцитарный лейкоз 46
Промиелоцитарный лейкоз 46
 М 2 пероксидаза 47
М 2 пероксидаза 47
 Острый лейкоз (миелобластный) Ретикулоциты % Нормобласты Гемоглобин ЦП – (цветовой показатель) Тромбоциты СОЭ +++ нет Мегалоциты 29 мм/ч нет Мегалобласты 32 х109/л + Пойкилоцитоз 0, 92 ++ Макроцитоз 58 г/л нет Анизоцитоз 1, 9 х1012/л 0, 2 Микроцитоз Количество эритроцитов нет НЕЙТРОФИЛЫ Количество лейкоцитов Б Э М Ю П С Л М 18 х109/л 0 0 1 4 21 2 Бласты -72%. Цитохимические реакции: пероксидаза (+), PAS (+) диффузная 48
Острый лейкоз (миелобластный) Ретикулоциты % Нормобласты Гемоглобин ЦП – (цветовой показатель) Тромбоциты СОЭ +++ нет Мегалоциты 29 мм/ч нет Мегалобласты 32 х109/л + Пойкилоцитоз 0, 92 ++ Макроцитоз 58 г/л нет Анизоцитоз 1, 9 х1012/л 0, 2 Микроцитоз Количество эритроцитов нет НЕЙТРОФИЛЫ Количество лейкоцитов Б Э М Ю П С Л М 18 х109/л 0 0 1 4 21 2 Бласты -72%. Цитохимические реакции: пероксидаза (+), PAS (+) диффузная 48
 М 4 альфа-нафтилэстераза и хлорацетэстераза 49
М 4 альфа-нафтилэстераза и хлорацетэстераза 49
 ФАБ классификация ОЛЛ • Т-лимфобластный (TALL) • В-лимфобластный (ВALL) • 0 -лимфобластный (CALL) • L 1 – малые мономорфные клетки • L 2 – большие гетерогенные клетки • L 3 – вакуолизированные беркитоподобные клетки 50
ФАБ классификация ОЛЛ • Т-лимфобластный (TALL) • В-лимфобластный (ВALL) • 0 -лимфобластный (CALL) • L 1 – малые мономорфные клетки • L 2 – большие гетерогенные клетки • L 3 – вакуолизированные беркитоподобные клетки 50
 Острый лимфобластный лейкоз ОЛЛ Норма 51
Острый лимфобластный лейкоз ОЛЛ Норма 51
 52
52
 ОЛЛ PAS 53
ОЛЛ PAS 53
 Вторичные изменения при лейкозах • анемический синдром • геморрагический синдром • интоксикационнный синдром • иммунодефицит • гиперпластический синдром • системные нарушения микроциркуляции (дисфункция эндотелия, лейкостаз и т. д. ) • метаболические нарушения 54
Вторичные изменения при лейкозах • анемический синдром • геморрагический синдром • интоксикационнный синдром • иммунодефицит • гиперпластический синдром • системные нарушения микроциркуляции (дисфункция эндотелия, лейкостаз и т. д. ) • метаболические нарушения 54
 Анемический синдром 55
Анемический синдром 55
 Геморрагический синдром 56
Геморрагический синдром 56
 Геморрагический синдром 57
Геморрагический синдром 57
 Некротические изменения на языке 58
Некротические изменения на языке 58
 Некрозы при нейтропении 59
Некрозы при нейтропении 59
 Candida albicans и Herpes symplex 60
Candida albicans и Herpes symplex 60
 Лимфаденопатия 61
Лимфаденопатия 61
 Увеличение лимфатических узлов средостения 62
Увеличение лимфатических узлов средостения 62
 СПЕЦИФИЧЕСКАЯ ИНФИЛЬТРАЦИЯ КОЖИ 63
СПЕЦИФИЧЕСКАЯ ИНФИЛЬТРАЦИЯ КОЖИ 63
 ОМЛ М 4 (гингивит) 64
ОМЛ М 4 (гингивит) 64
 Нейролейкемия (бласты в ликворе) 65
Нейролейкемия (бласты в ликворе) 65
 66
66
 67
67
 Хронический лимфолейкоз Количество эритроцитов Ретикулоциты % 2, 8 х1012/л 4 Нормобласты нет Анизоцитоз Гемоглобин ЦП – (цветовой показатель) Тромбоциты СОЭ ++ Мегалобласты нет Мегалоциты 51 мм/ч нет Пойкилоцитоз 70 х109/л нет Макроцитоз 0, 9 + Микроцитоз 85 г/л нет НЕЙТРОФИЛЫ Количество лейкоцитов Б Э М Ю П С Л М 120 х109/л 0 1 0 0 1 20 74 4 Тени Боткина – Гумпрехта 8: 100 68
Хронический лимфолейкоз Количество эритроцитов Ретикулоциты % 2, 8 х1012/л 4 Нормобласты нет Анизоцитоз Гемоглобин ЦП – (цветовой показатель) Тромбоциты СОЭ ++ Мегалобласты нет Мегалоциты 51 мм/ч нет Пойкилоцитоз 70 х109/л нет Макроцитоз 0, 9 + Микроцитоз 85 г/л нет НЕЙТРОФИЛЫ Количество лейкоцитов Б Э М Ю П С Л М 120 х109/л 0 1 0 0 1 20 74 4 Тени Боткина – Гумпрехта 8: 100 68
 Хронический миелолейкоз Хронический лимфолейкоз 69
Хронический миелолейкоз Хронический лимфолейкоз 69
 Хронический лимфолейкоз Тени Гумпрехта-Боткина 70
Хронический лимфолейкоз Тени Гумпрехта-Боткина 70
 Хронический лимфолейкоз 71
Хронический лимфолейкоз 71
Хронический миелолейкоз 72
Хронический миелолейкоз 72
 Филадельфийская хромосома (Ph): t(9; 22) 9 9 q+ 22 Ph ( or 22 q-) bcr-abl БЕЛОК С ПОВЫШЕННОЙ ТИРОЗИНКИНАЗНОЙ АКТИВНОСТЬЮ abl p 210 bcr-abl CML 73
Филадельфийская хромосома (Ph): t(9; 22) 9 9 q+ 22 Ph ( or 22 q-) bcr-abl БЕЛОК С ПОВЫШЕННОЙ ТИРОЗИНКИНАЗНОЙ АКТИВНОСТЬЮ abl p 210 bcr-abl CML 73
 Филадельфийская хромосома t(9; 22) транслокация 74
Филадельфийская хромосома t(9; 22) транслокация 74
 Молекулярные методы выявления Ph хромосомы Флюоресценция в локусах гибридизации Интерфаза Метафаза 75
Молекулярные методы выявления Ph хромосомы Флюоресценция в локусах гибридизации Интерфаза Метафаза 75
 Фазы ХМЛ Прогрессия Хроническая Бластный фаза Фаза акселерации криз Стабилизация в течение 4 -6 лет Продолжительность до 1 года Выживаемость 3 -6 месяцев Терминальная фаза 76
Фазы ХМЛ Прогрессия Хроническая Бластный фаза Фаза акселерации криз Стабилизация в течение 4 -6 лет Продолжительность до 1 года Выживаемость 3 -6 месяцев Терминальная фаза 76
 Схематичное изображение лейкоцитарной формулы Бласты Зрелые клетки Острый лейкоз ХМЛ, хроническая стадия ХМЛ, острая стадия 77
Схематичное изображение лейкоцитарной формулы Бласты Зрелые клетки Острый лейкоз ХМЛ, хроническая стадия ХМЛ, острая стадия 77
 ХМЛ, хроническая фаза Количество эритроцитов Ретикулоциты % 0, 4 Нормобласты 2, 9 х1012/л нет Анизоцитоз Гемоглобин ЦП – (цветовой показатель) Тромбоциты нет Пойкилоцитоз нет Мегалоциты 35 мм/ч + Мегалобласты 150 х109/л СОЭ нет Макроцитоз 0, 95 + Микроцитоз 92 г/л нет НЕЙТРОФИЛЫ Количество лейкоцитов Б Э М Ю П С Л М 182 х109/л 3 2 7 8 15 39 3 16 Бласты -2%, промиелоциты – 5% Ph (+) в 20 из 30 митозов. Цитогенетика – t (9, 22) 78
ХМЛ, хроническая фаза Количество эритроцитов Ретикулоциты % 0, 4 Нормобласты 2, 9 х1012/л нет Анизоцитоз Гемоглобин ЦП – (цветовой показатель) Тромбоциты нет Пойкилоцитоз нет Мегалоциты 35 мм/ч + Мегалобласты 150 х109/л СОЭ нет Макроцитоз 0, 95 + Микроцитоз 92 г/л нет НЕЙТРОФИЛЫ Количество лейкоцитов Б Э М Ю П С Л М 182 х109/л 3 2 7 8 15 39 3 16 Бласты -2%, промиелоциты – 5% Ph (+) в 20 из 30 митозов. Цитогенетика – t (9, 22) 78
 ХМЛ, острая фаза Ретикулоциты % Нормобласты Гемоглобин ЦП – (цветовой показатель) Тромбоциты СОЭ +++ нет Мегалоциты 17 мм/ч нет Мегалобласты 260 х109/л нет Пойкилоцитоз 0, 85 ++ Макроцитоз 98 г/л нет Анизоцитоз 3, 6 х1012/л 2, 1 Микроцитоз Количество эритроцитов нет НЕЙТРОФИЛЫ Количество лейкоцитов Б Э М Ю П С Л М 31, 5 х109/л 1 0, 5 3, 5 7, 5 6, 5 40 20 2 Бласты -22%, промиелоциты – 2% Множественные обломки ядер мегакариоцитов 79
ХМЛ, острая фаза Ретикулоциты % Нормобласты Гемоглобин ЦП – (цветовой показатель) Тромбоциты СОЭ +++ нет Мегалоциты 17 мм/ч нет Мегалобласты 260 х109/л нет Пойкилоцитоз 0, 85 ++ Макроцитоз 98 г/л нет Анизоцитоз 3, 6 х1012/л 2, 1 Микроцитоз Количество эритроцитов нет НЕЙТРОФИЛЫ Количество лейкоцитов Б Э М Ю П С Л М 31, 5 х109/л 1 0, 5 3, 5 7, 5 6, 5 40 20 2 Бласты -22%, промиелоциты – 2% Множественные обломки ядер мегакариоцитов 79
 Гепатоспленомегалия 80
Гепатоспленомегалия 80
 Картина периферической крови Острый лейкоз ХМЛ, хроническая стадия 81
Картина периферической крови Острый лейкоз ХМЛ, хроническая стадия 81
 Истинная полицитемия Ø Увеличение количества эритроцитов Ø Нормальные Ра. О 2 и уровень ЭПО Ø Тромбоцитоз > 400 • 109/л Ø Увеличение нейтрофилов > 10 • 109/л Ø Спленомегалия 82
Истинная полицитемия Ø Увеличение количества эритроцитов Ø Нормальные Ра. О 2 и уровень ЭПО Ø Тромбоцитоз > 400 • 109/л Ø Увеличение нейтрофилов > 10 • 109/л Ø Спленомегалия 82
 Эритропоэтин Гликопротеид, 105 к. Да Период полужизни в крови 4 -13 час Основные стимуляторы образования ЭПО: • • гипоксия андрогены монооксид углерода продукты гемолиза Действие ЭПО на эритропоэз: • • стимулирует пролиферацию КОЕ-ГММЭ, КОЕ-Эр. Мег. , КОЕ-Эр. стимулирует дифференциацию КОЕ-Эр. в проэритробласты укорачивает время интермитотического периода укорачивает время выхода ретикулоцитов из костного мозга 83
Эритропоэтин Гликопротеид, 105 к. Да Период полужизни в крови 4 -13 час Основные стимуляторы образования ЭПО: • • гипоксия андрогены монооксид углерода продукты гемолиза Действие ЭПО на эритропоэз: • • стимулирует пролиферацию КОЕ-ГММЭ, КОЕ-Эр. Мег. , КОЕ-Эр. стимулирует дифференциацию КОЕ-Эр. в проэритробласты укорачивает время интермитотического периода укорачивает время выхода ретикулоцитов из костного мозга 83
 Причины эритроцитозов • гипоксия • ишемия почек • избыточное образование андрогенов • эритропоэтинпродуцирующие опухоли • гемоконцентрация 84
Причины эритроцитозов • гипоксия • ишемия почек • избыточное образование андрогенов • эритропоэтинпродуцирующие опухоли • гемоконцентрация 84
 Истинная полицитемия (болезнь Вакеза) Количество эритроцитов Ретикулоциты % 6, 2 х1012/л 2 Нормобласты Анизоцитоз Гемоглобин ЦП – (цветовой показатель) Тромбоциты нет Пойкилоцитоз нет Мегалоциты 1 мм/ч + Мегалобласты 580 х109/л СОЭ нет Макроцитоз 0, 9 нет Микроцитоз 186 г/л нет НЕЙТРОФИЛЫ Количество лейкоцитов Б Э М Ю П С Л М 16 х109/л 1 3 2 3 5 62 19 5 Гематокрит – 50% Уровень эритропоэтина в крови 7 Ед/л (норма – 5 -25 Ед/л) 85
Истинная полицитемия (болезнь Вакеза) Количество эритроцитов Ретикулоциты % 6, 2 х1012/л 2 Нормобласты Анизоцитоз Гемоглобин ЦП – (цветовой показатель) Тромбоциты нет Пойкилоцитоз нет Мегалоциты 1 мм/ч + Мегалобласты 580 х109/л СОЭ нет Макроцитоз 0, 9 нет Микроцитоз 186 г/л нет НЕЙТРОФИЛЫ Количество лейкоцитов Б Э М Ю П С Л М 16 х109/л 1 3 2 3 5 62 19 5 Гематокрит – 50% Уровень эритропоэтина в крови 7 Ед/л (норма – 5 -25 Ед/л) 85
 Эритроцитоз (абсолютный) Количество эритроцитов Ретикулоциты % 6, 1 х1012/л 3 Нормобласты нет Анизоцитоз Гемоглобин ЦП – (цветовой показатель) Тромбоциты нет Пойкилоцитоз нет Мегалоциты 2 мм/ч + Мегалобласты 270 х109/л СОЭ нет Макроцитоз 0, 86 + Микроцитоз 175 г/л нет НЕЙТРОФИЛЫ Количество лейкоцитов Б Э М Ю П С Л М 5, 8 х109/л 0 2 0 0 3 55 34 6 Гематокрит – 54% Уровень эритропоэтина в крови – 45 Ед/л (норма 5 -25 Ед/л) 86
Эритроцитоз (абсолютный) Количество эритроцитов Ретикулоциты % 6, 1 х1012/л 3 Нормобласты нет Анизоцитоз Гемоглобин ЦП – (цветовой показатель) Тромбоциты нет Пойкилоцитоз нет Мегалоциты 2 мм/ч + Мегалобласты 270 х109/л СОЭ нет Макроцитоз 0, 86 + Микроцитоз 175 г/л нет НЕЙТРОФИЛЫ Количество лейкоцитов Б Э М Ю П С Л М 5, 8 х109/л 0 2 0 0 3 55 34 6 Гематокрит – 54% Уровень эритропоэтина в крови – 45 Ед/л (норма 5 -25 Ед/л) 86
 Т-клеточная лимфома (кожа) 87
Т-клеточная лимфома (кожа) 87
 Ходжкинская лимфома 88
Ходжкинская лимфома 88


